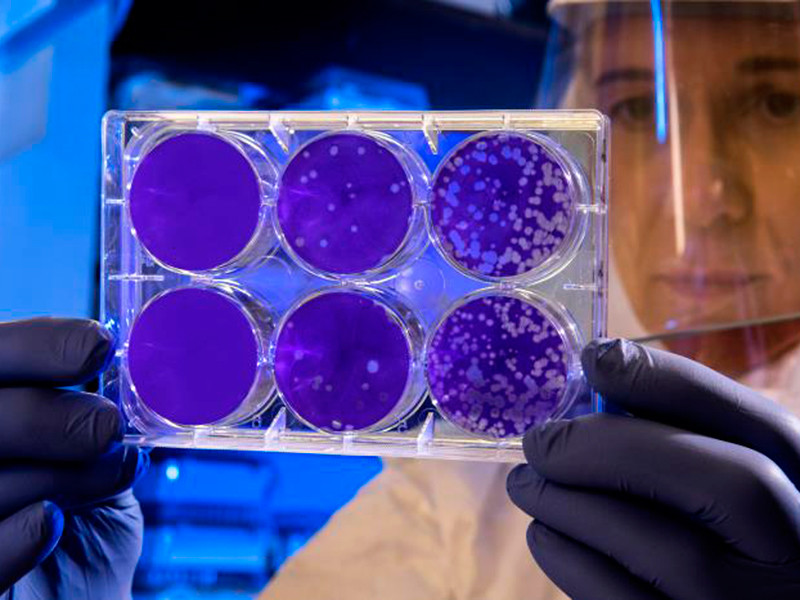

Китайский коронавирус, от которого умерли уже 9 человек, добрался до США и назван угрозой для россиян
Центры по контролю и профилактике заболеваний в США (Centers for Disease Control and Prevention, CDC) подтвердили первый в стране случай заболевания коронавирусом из Китая.
Речь идет о пациенте, который 15 января вернулся в штат Вашингтон из Китая. По возвращении из поездки он обратился к медикам, которые заподозрили у обратившегося новый коронавирус, в том числе из-за проявившихся симптомов заболевания. Дальнейшие анализы подтвердили этот диагноз. По данным газеты Washington Post, заболевший прилетел из Китая до того, как федеральные службы здравоохранения начали проверять путешественников в трех крупнейших аэропортах США.
В связи с выявленным случаем заболевания страны Центральной Америки усиливают эпидемиологическое наблюдение за состоянием прибывших. В частности, в международном аэропорту Гватемалы будет создан специальный пункт, чтобы предотвратить проникновение вируса в страну. Меры санитарной безопасности также усиливают минздравы Панамы, Коста-Рики и Никарагуа.
Между тем число скончавшихся от нового типа коронавируса в Китае достигло девяти человек, выявлено 440 подтвержденных случаев заражения. Об этом заявил на пресс-конференции заместитель главы государственного комитета КНР по вопросам гигиены и здоровья Ли Бинь, которого цитирует РИА "Новости".
"Существует возможность мутации вируса и его дальнейшего распространения", - сказал чиновник, отметив, что на данный момент выявлен респираторный путь попадания вируса в организм человека. Он призвал население страны и иностранцев воздерживаться от посещения города Уханя даже в дни "Праздника весны" - Нового года по лунному календарю, когда по традиции семьи собираются вместе. Власти КНДР также приняли решение временно закрыть границу для иностранных туристов, сообщило агентство Reuters со ссылкой на базирующееся в Китае туристическое агентство Young Pioneer Tours (YPT).
Ли Бинь признал, что именно Ухань является центром распространения пневмонии, вызываемой новым типом коронавируса. "Можно сказать, что вспышка в Ухане локализована, сейчас основное внимание уделяется профилактике и борьбе с этой болезнью", - заявил он, добавив, что власти Китая при появлении вируса незамедлительно проинформировали о нем ВОЗ и соседние с Китаем страны, включая Россию.
Руководитель китайского Центра по контролю и профилактике заболеваний академик Гао Фу подтвердил, что источником коронавируса стали дикие животные, которыми незаконно торговали на уханьском рынке. В среду о первом случае заражения новым типом коронавируса сообщили власти Макао. По их данным, вирус обнаружен у 52-летней женщины, приехавшей в Макао из Уханя. Она поступила в местный госпиталь во вторник днем с пневмонией, вызванной новым типом коронавируса, передает "Интерфакс".
В РФ также признали опасность нового типа коронавируса 2019-nCoV, распространяющегося в Китае, сообщает ТАСС. Об этом заявил заместитель министра здравоохранения РФ Сергей Краевой при обсуждении в первом чтении в Госдуме правительственного законопроекта о биологической безопасности РФ. По его словам, статья 7 этого документа "как раз посвящена основным биологическим угрозам, опасностям", одной из которых является инфекция, вызванная коронавирусом.
Напомним, в феврале Минздрав подготовит экспресс-тест на выявление нового коронавируса, к работе над вакциной от этого вируса также приступил американский Национальный институт здравоохранения (NIH). Ученые предупредили, что первые клинические испытания вакцины пройдут не ранее, чем через несколько месяцев, а доступной вакцина станет не раньше, чем через год.
Между тем InoPressa приводит перевод статьи, авторы которой вспоминают об эпидемии SARS: в период с ноября 2002 по июль 2003 года вирусом заразились более 8 тысяч человек примерно в 30 странах, 774 человека умерли. "Тогда правительство Китая вызвало гнев населения, так как оно прилагало все усилия для того, чтобы скрыть масштаб эпидемии. В результате необходимые меры для борьбы с ней не были приняты своевременно", - пишут авторы.
Сейчас правительство информирует китайцев лучше, чем в случае с SARS, вопрос о том, можно ли действительно верить официальным сообщениям, остается открытым. А авторы исследования Имперского колледжа в Лондоне полагают, что официальные данные весьма серьезно занижены. По их словам, только в Ухане 12 января этого года было уже более 1,7 тыс. зараженных.